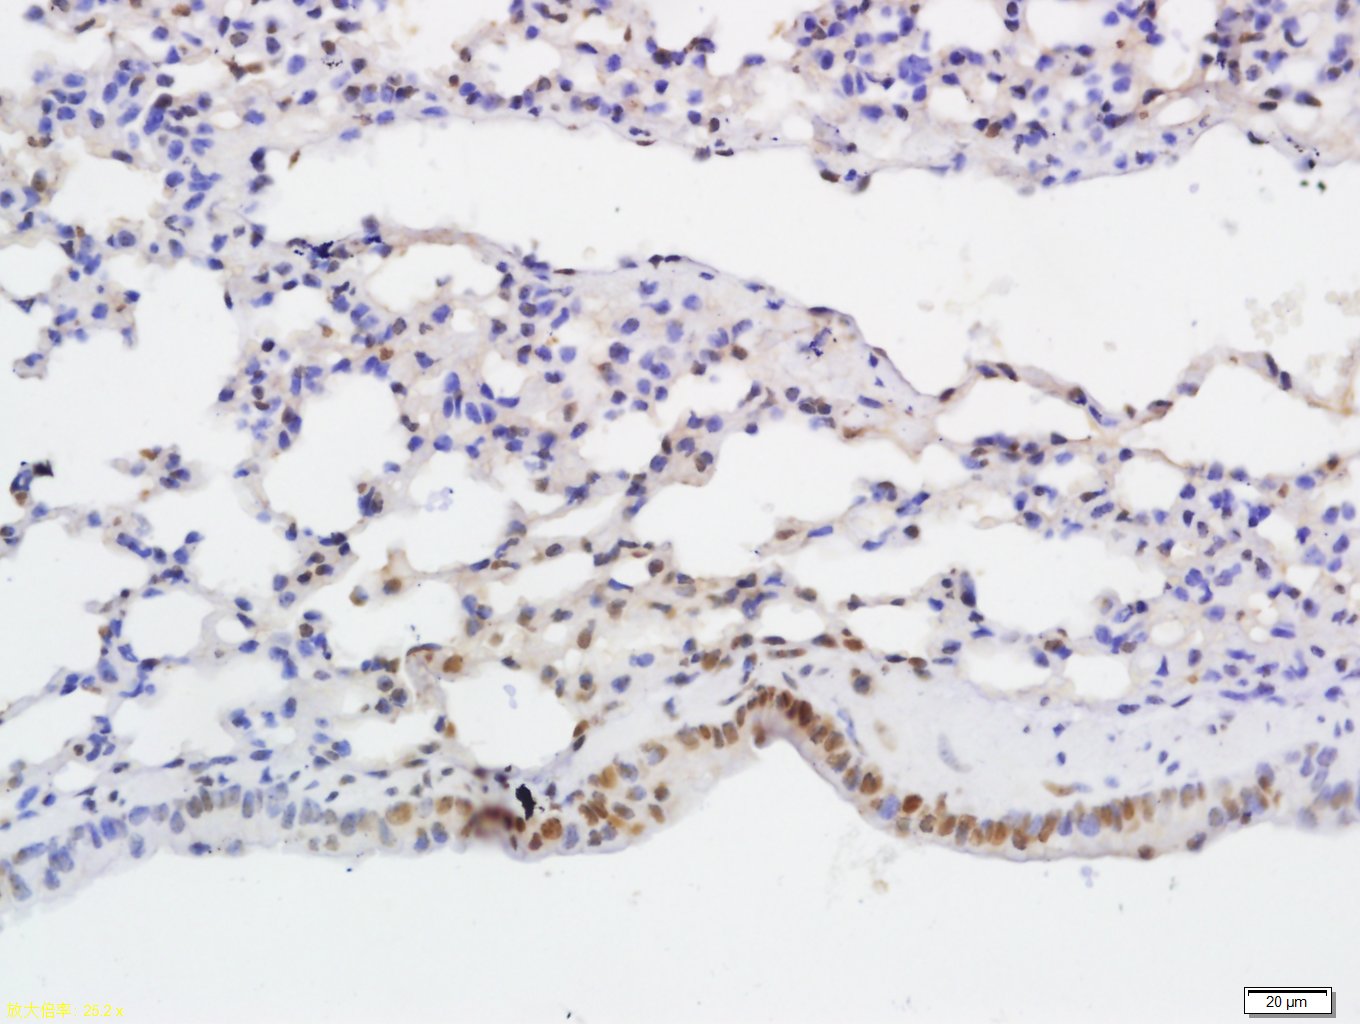
NFKB p65 (Acetyl-Lys314/Lys315

相关产品推荐更多 >
万千商家帮你免费找货
0 人在求购买到急需产品
- 详细信息
- 文献和实验
- 技术资料
- 应用范围:
产品信息以Bioss网站为准
- 规格:
50ul/100ul/200ul/200ug
| 规格: | 50ul | 产品价格: | ¥1180.0 |
|---|---|---|---|
| 规格: | 100ul | 产品价格: | ¥1980.0 |
| 规格: | 200ul | 产品价格: | ¥2800.0 |
| 规格: | 200ug | 产品价格: | ¥5600.0 |
| 产品编号 | bsm-33387M |
| 英文名称 | NFKB p65 (Acetyl-Lys314/Lys315) Mouse mAb |
| 中文名称 | 乙酰化细胞核因子(K314/K315)单克隆抗体 |
| 英文别名 | TF65_HUMAN; Transcription factor p65; RELA; Nuclear factor NF-kappa-B p65 subunit; Nuclear factor of kappa light polypeptide gene enhancer in B-cells 3; NFKB3; RELA proto-oncogene, NF-kB subunit; p65; CMCU; NFKB3; AIF3BL3; NF-kB p65/RelA; NFκB-p65; NFκB p65; NF κB-p65; NFκBp65; |
| 产品应用 | IHC-P=1:100-500, IHC-F=1:100-500, IF=1:100-500 Not yet tested in other applications. |
| 交叉反应 | Human, Mouse, Rat |
| 抗体来源 | Mouse |
| 免疫原 | KLH conjugated Synthesised acetylpeptide derived from human NFKBp65 around the acetylation site of Lys314/315 |
| 亚型 | IgG |
| 性状 | Liquid |
| 纯化方法 | affinity purified by Protein G |
| 克隆类型 | Monoclonal |
| 理论分子量 | 61 kDa |
| 浓度 | 1mg/ml |
| 储存液 | 0.01M TBS (pH7.4) with 1% BSA, 0.02% Proclin300 and 50% Glycerol. |
| 研究领域 | Cancer > Cell Death > Apoptosis > Apoptosis Markers > NFkB > RelA (p65) Cancer > Signal transduction > Nuclear signaling > NFkB pathway Cardiovascular > Atherosclerosis > Vascular Inflammation > Inflammatory mediators Cell Biology > Apoptosis > Intracellular > NFkB > RelA (p65) Epigenetics and Nuclear Signaling > Nuclear Signaling Pathways > NFkB pathway Metabolism > Types of disease > Obesity Microbiology > Interspecies Interaction > Host Immune Response Microbiology > Interspecies Interaction > Host Virus Interaction Neuroscience > Neurology process > Neurodegenerative disease > Alzheimer's disease Signal Transduction > Signaling Pathway > Nuclear Signaling > NFkB Pathway |
| 亚基 | Component of the NF-kappa-B p65-p50 complex. Component of the NF-kappa-B p65-c-Rel complex. Homodimer; component of the NF-kappa-B p65-p65 complex. Component of the NF-kappa-B p65-p52 complex. May interact with ETHE1. Binds AES and TLE1. Interacts with TP53BP2. Binds to and is phosphorylated by the activated form of either RPS6KA4 or RPS6KA5. Interacts with ING4 and this interaction may be indirect. Interacts with CARM1, USP48 and UNC5CL. Interacts with IRAK1BP1. Interacts with NFKBID. Interacts with NFKBIA. Interacts with GSK3B. Interacts with NFKBIB. Interacts with NFKBIE. Interacts with NFKBIZ. Interacts with EHMT1 (via ANK repeats). Part of a 70-90 kDa complex at least consisting of CHUK, IKBKB, NFKBIA, RELA, IKBKAP and MAP3K14. Interacts with HDAC3; HDAC3 mediates the deacetylation of RELA. Interacts with HDAC1; the interaction requires non-phosphorylated RELA. Interacts with CBP; the interaction requires phosphorylated RELA. Interacts (phosphorylated at 'Thr-254') with PIN1; the interaction inhibits p65 binding to NFKBIA. Interacts with SOCS1. Interacts with UXT. Interacts with MTDH and PHF11. Interacts with ARRB2. Interacts with human respiratory syncytial virus (HRSV) protein M2-1. Interacts with NFKBIA (when phosphorylated), the interaction is direct; phosphorylated NFKBIA is part of a SCF(BTRC)-like complex lacking CUL1. Interacts with RNF25. Interacts (via C-terminus) with DDX1. Interacts with UFL1 and COMMD1. Interacts with BRMS1; this promotes deacetylation of 'Lys-310'. Interacts with NOTCH2. Directly interacts with MEN1; this interaction represses NFKB-mediated transactivation. Interacts with AKIP1, which promotes the phosphorylation and nuclear retention of RELA. Interacts (via the RHD) with GFI1; the interaction, after bacterial lipopolysaccharide (LPS) stimulation, inhibits the transcriptional activity by interfering with the DNA-binding activity to target gene promoter DNA. |
| 亚细胞定位 | Nucleus. Cytoplasm. Note=Colocalized with DDX1 in the nucleus upon TNF-alpha induction. Nuclear, but also found in the cytoplasm in an inactive form complexed to an inhibitor (I-kappa-B). Colocalizes with GFI1 in the nucleus after LPS stimulation. |
| 翻译后修饰 | Ubiquitinated, leading to its proteasomal degradation. Degradation is required for termination of NF-kappa-B response.
Monomethylated at Lys-310 by SETD6. Monomethylation at Lys-310 is recognized by the ANK repeats of EHMT1 and promotes the formation of repressed chromatin at target genes, leading to down-regulation of NF-kappa-B transcription factor activity. Phosphorylation at Ser-311 disrupts the interaction with EHMT1 without preventing monomethylation at Lys-310 and relieves the repression of target genes. Phosphorylation at Ser-311 disrupts the interaction with EHMT1 and promotes transcription factor activity. Phosphorylation on Ser-536 stimulates acetylation on Lys-310 and interaction with CBP; the phosphorylated and acetylated forms show enhanced transcriptional activity. Phosphorylation at Ser-276 by RPS6KA4 and RPS6KA5 promotes its transactivation and transcriptional activities. Reversibly acetylated; the acetylation seems to be mediated by CBP, the deacetylation by HDAC3 and SIRT2. Acetylation at Lys-122 enhances DNA binding and impairs association with NFKBIA. Acetylation at Lys-310 is required for full transcriptional activity in the absence of effects on DNA binding and NFKBIA association. Acetylation can also lower DNA-binding and results in nuclear export. Interaction with BRMS1 promotes deacetylation of Lys-310. Lys-310 is deacetylated by SIRT2. S-nitrosylation of Cys-38 inactivates the enzyme activity. Sulfhydration at Cys-38 mediates the anti-apoptotic activity by promoting the interaction with RPS3 and activating the transcription factor activity. Sumoylation by PIAS3 negatively regulates DNA-bound activated NF-kappa-B. |
| 相似性 | Contains 1 RHD (Rel-like) domain. |
| 功能 | NF-kappa-B is a pleiotropic transcription factor present in almost all cell types and is the endpoint of a series of signal transduction events that are initiated by a vast array of stimuli related to many biological processes such as inflammation, immunity, differentiation, cell growth, tumorigenesis and apoptosis. NF-kappa-B is a homo- or heterodimeric complex formed by the Rel-like domain-containing proteins RELA/p65, RELB, NFKB1/p105, NFKB1/p50, REL and NFKB2/p52 and the heterodimeric p65-p50 complex appears to be most abundant one. The dimers bind at kappa-B sites in the DNA of their target genes and the individual dimers have distinct preferences for different kappa-B sites that they can bind with distinguishable affinity and specificity. Different dimer combinations act as transcriptional activators or repressors, respectively. NF-kappa-B is controlled by various mechanisms of post-translational modification and subcellular compartmentalization as well as by interactions with other cofactors or corepressors. NF-kappa-B complexes are held in the cytoplasm in an inactive state complexed with members of the NF-kappa-B inhibitor (I-kappa-B) family. In a conventional activation pathway, I-kappa-B is phosphorylated by I-kappa-B kinases (IKKs) in response to different activators, subsequently degraded thus liberating the active NF-kappa-B complex which translocates to the nucleus. NF-kappa-B heterodimeric p65-p50 and p65-c-Rel complexes are transcriptional activators. The NF-kappa-B p65-p65 complex appears to be involved in invasin-mediated activation of IL-8 expression. The inhibitory effect of I-kappa-B upon NF-kappa-B the cytoplasm is exerted primarily through the interaction with p65. p65 shows a weak DNA-binding site which could contribute directly to DNA binding in the NF-kappa-B complex. Associates with chromatin at the NF-kappa-B promoter region via association with DDX1. |
| 保存条件 | Shipped at 4℃. Store at -20℃ for one year. Avoid repeated freeze/thaw cycles. |
| 注意事项 | This product as supplied is intended for research use only, not for use in human, therapeutic or diagnostic applications. |
| 背景资料 | NF-kappa-B is a ubiquitous transcription factor involved in several biological processes. It is held in the cytoplasm in an inactive state by specific inhibitors. Upon degradation of the inhibitor, NF-kappa-B moves to the nucleus and activates transcription of specific genes. NF-kappa-B is composed of NFKB1 or NFKB2 bound to either REL, RELA, or RELB. The most abundant form of NF-kappa-B is NFKB1 complexed with the product of this gene, RELA. Four transcript variants encoding different isoforms have been found for this gene. [provided by RefSeq, Sep 2011]. |
| 应用 | 推荐稀释比例 |
| {IHC-P} | {1:100-500} |
| {IHC-F} | {1:100-500} |
| {IF} | {1:100-500} |

风险提示:丁香通仅作为第三方平台,为商家信息发布提供平台空间。用户咨询产品时请注意保护个人信息及财产安全,合理判断,谨慎选购商品,商家和用户对交易行为负责。对于医疗器械类产品,请先查证核实企业经营资质和医疗器械产品注册证情况。
文献和实验[IF={{ 3.7 }}] {Yuting Wang. et al. ARA290 Attenuates Apical Periodontitis via SIRT1/NF-κB/IL-1β Pathway Modulation. INT DENT J. 2025 Oct;75:100863} {IHC,IF} {Mouse}
【求助】新手 请问western-blot测NF-KB、FLT3是用总蛋白提取试剂盒吗
1 为什么要用细胞总蛋白做p65,而不用胞核蛋白呢?这样胞浆的IKBα的水平和胞核NF-κB的水平是不是也可以的? 2 有些因子是通过促进P65核转位(自IkB解离,而IkB量并不变),就是说IKB自解离,那实际上在NF-κB入核的过程中,胞浆的IKB用western做是不是也应该增加啊? 还是说在IKB没解离前,一抗就能和IKBα结合? 1 测NFkB活性变化,对于非磷酸化抗体,必须做核蛋白的western或EMSA,这是反映NFkB有无功能改变;如果核蛋白有变
涕零! yanranpiaoyun MARK hypercyte 这里有NFκB (p65) Rabbit Polyclonal和NFκB (p65) Mouse Monoclonal的产品链接: http://www.hypercyte.com/product/showproduct.php?id=1316&lang=cn http://www.hypercyte.com/product/showproduct.php?id
技术资料暂无技术资料 索取技术资料









